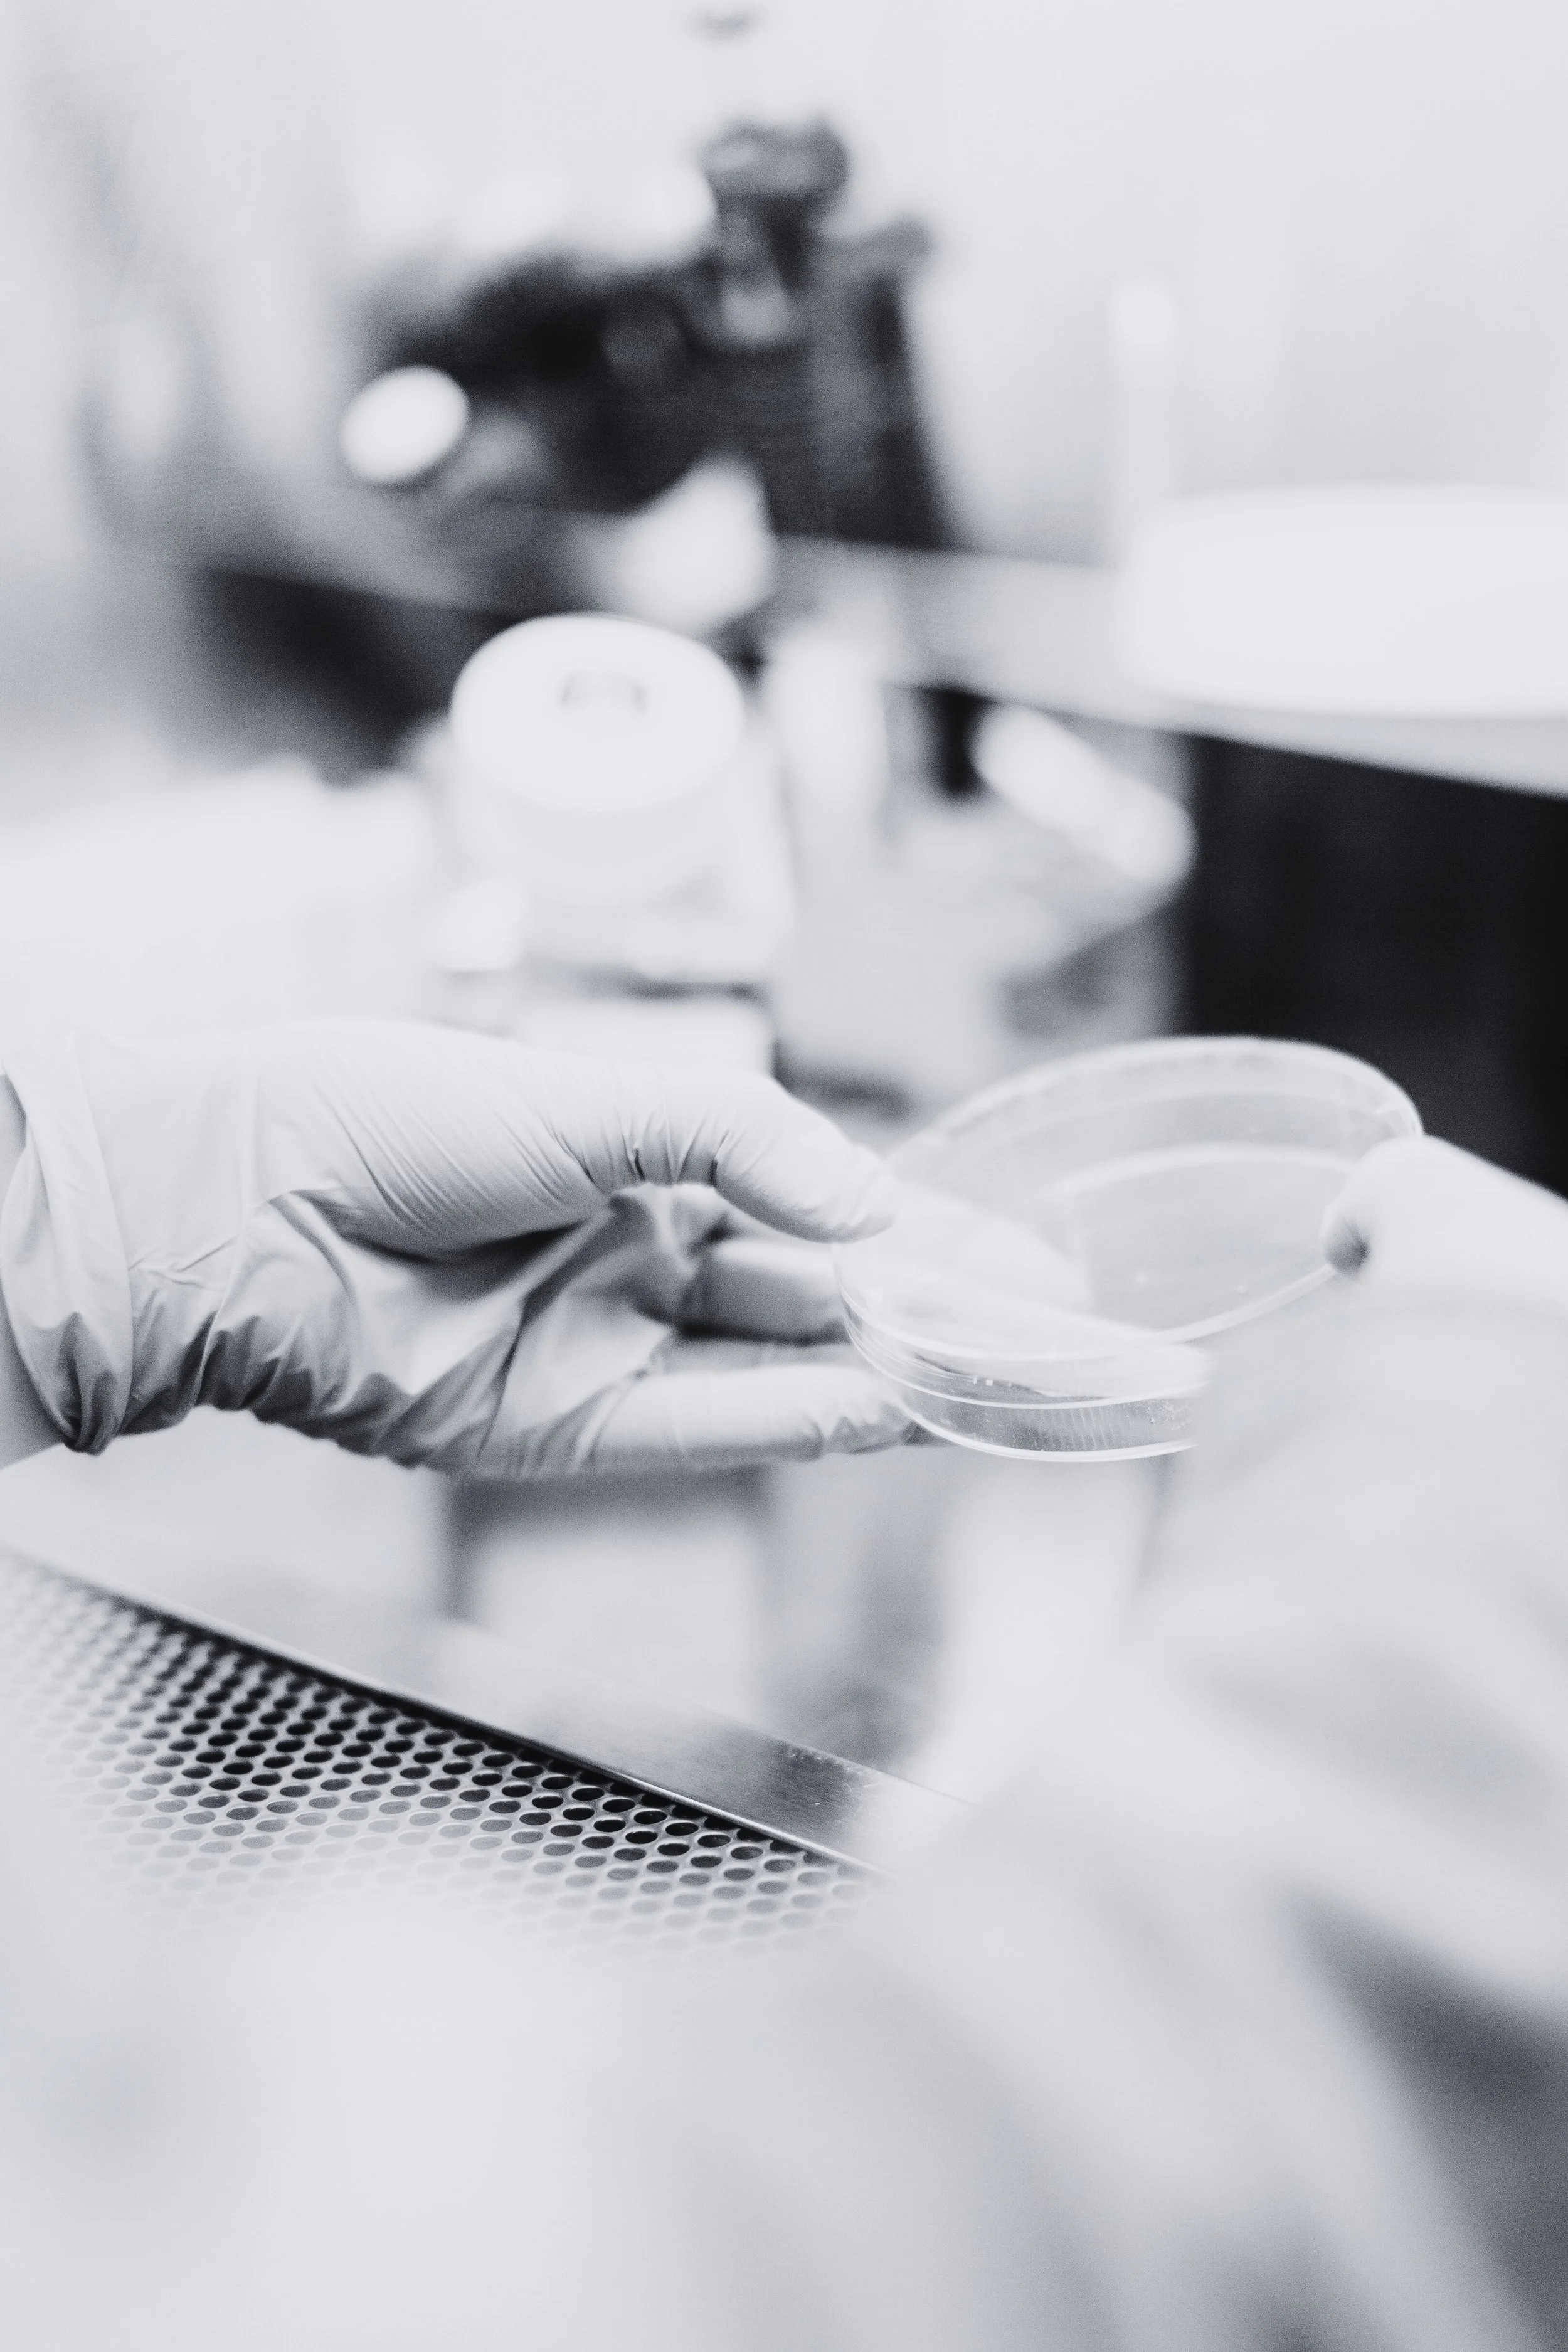

Cardiac Organoid & Stem Cell Expertise - On Demand
Accelerating translational cardiac research.
Expert cardiac organoid and stem cell consulting for translational research.
We specialize in cardiac biology, human pluripotent stem cells (hPSCs/hiPSCs), and organoid-based disease modeling. We support biotech and academic teams in developing, optimizing, and troubleshooting stem-cell–derived cardiac platforms. Planned products include specialized cardiac differentiation media and organoid reagents.

Consulting Services
Expert support in cardiac stem cell systems and organoid model development.

Areas of Technical Expertise
Technical depth in stem cell biology, cardiac lineage, and organoid modeling.
Entrain Bio Inc.
Cardiac organoid and stem cell consulting.
For inquiries: info@entrainbio.com
© 2025 Entrain Bio Inc. All rights reserved.